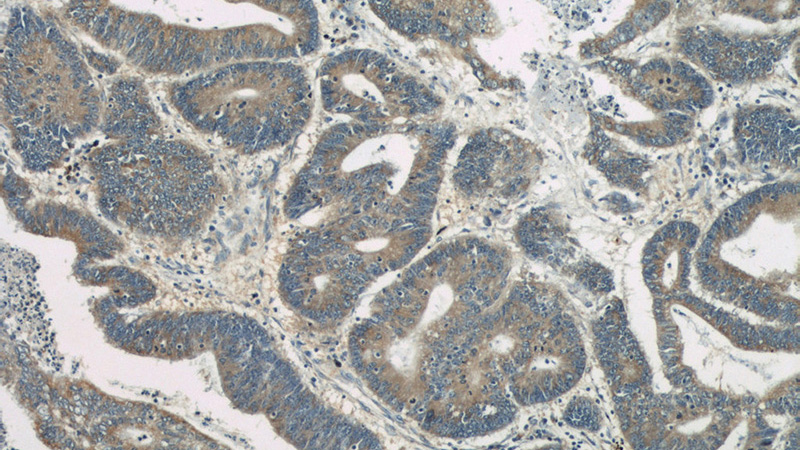
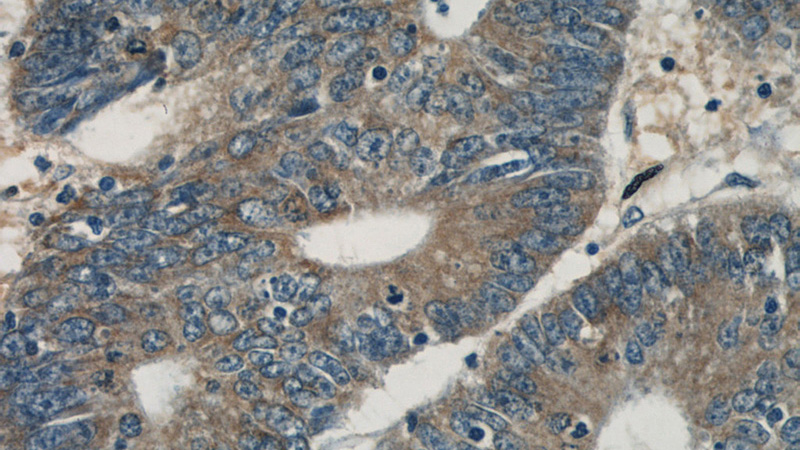

-
Product Name
LDLR antibody
- Documents
-
Description
LDLR Rabbit Polyclonal antibody. Positive WB detected in mouse brain tissue, HeLa cells, HL-60 cells, human brain tissue, Jurkat cells, NIH/3T3 cells, Raji cells. Positive IP detected in HeLa cells. Positive FC detected in HeLa cells. Positive IHC detected in human colon cancer tissue, human brain tissue, human pancreas tissue. Observed molecular weight by Western-blot: 150-160 kDa
-
Tested applications
ELISA, WB, IHC, IP, FC
-
Species reactivity
Human, Mouse; other species not tested.
-
Alternative names
FHC antibody; LDL receptor antibody; LDLR antibody
-
Isotype
Rabbit IgG
-
Preparation
This antibody was obtained by immunization of LDLR recombinant protein (Accession Number: NM_000527). Purification method: Antigen affinity purified.
-
Clonality
Polyclonal
-
Formulation
PBS with 0.1% sodium azide and 50% glycerol pH 7.3.
-
Storage instructions
Store at -20℃. DO NOT ALIQUOT
-
Applications
Recommended Dilution:
WB: 1:200-1:2000
IP: 1:200-1:2000
IHC: 1:20-1:200
-
Validations

mouse brain tissue were subjected to SDS PAGE followed by western blot with Catalog No:112188(LDLR antibody) at dilution of 1:300
Immunohistochemical of paraffin-embedded human colon cancer using Catalog No:112188(LDLR antibody) at dilution of 1:50 (under 10x lens)
Immunohistochemical of paraffin-embedded human colon cancer using Catalog No:112188(LDLR antibody) at dilution of 1:50 (under 40x lens)

IP Result of anti-LDLR (IP:Catalog No:112188, 5ug; Detection:Catalog No:112188 1:500) with HeLa cells lysate 1200ug.

1X10^6 HeLa cells were stained with .2ug LDLR antibody (Catalog No:112188, red) and control antibody (blue). Fixed with 4% PFA blocked with 3% BSA (30 min). Alexa Fluor 488-congugated AffiniPure Goat Anti-Rabbit IgG(H+L) with dilution 1:1500.
-
Background
LDLR (low density lipoprotein receptor) is a member of the LDL receptor gene family and is involved in receptor-mediated endocytosis of specific ligands. The LDLR is a cell surface glycoproteins that scavenge LDL from the blood and regulate plasma LDL cholesterol. The cytoplasmic domain of the LDL receptor is necessary for the receptor to cluster in coated pits, which promotes the rapid endocytosis of bound LDL. The protein is highly glycosylated through N- and O-linkages and thus migrates at 100 to 160 kDa bands on SDS-PAGE.
-
References
- Zhang Y, Yang X, Bian F. TNF-α promotes early atherosclerosis by increasing transcytosis of LDL across endothelial cells: crosstalk between NF-κB and PPAR-γ. Journal of molecular and cellular cardiology. 72:85-94. 2014.
- Chen Y, Liu M, Zhao T. Danhong injection inhibits the development of atherosclerosis in both Apoe⁻/⁻ and Ldlr⁻/⁻ mice. Journal of cardiovascular pharmacology. 63(5):441-52. 2014.
- Duan Y, Fu W, Wang S, Ni Y, Zhao R. Cholesterol deregulation induced by chronic corticosterone (CORT) stress in pectoralis major of broiler chickens. Comparative biochemistry and physiology. Part A, Molecular & integrative physiology. 176:59-64. 2014.
- He K, Ye X, Wu H. The safety and anti-hypercholesterolemic effect of coptisine in Syrian golden hamsters. Lipids. 50(2):185-94. 2015.
- Liu J, Duan Y, Hu Y. Exogenous administration of chronic corticosterone affects hepatic cholesterol metabolism in broiler chickens showing long or short tonic immobility. Comparative biochemistry and physiology. Part A, Molecular & integrative physiology. 191:53-8. 2016.
- Liu M, Zhang W, Li X, Han J, Chen Y, Duan Y. Impact of age and sex on the development of atherosclerosis and expression of the related genes in apoE deficient mice. Biochemical and biophysical research communications. 469(3):456-62. 2016.
- Yuan ZY, Lu X, Lei F. TATA boxes in gene transcription and poly (A) tails in mRNA stability: New perspective on the effects of berberine. Scientific reports. 5:18326. 2015.
Related Products / Services
Please note: All products are "FOR RESEARCH USE ONLY AND ARE NOT INTENDED FOR DIAGNOSTIC OR THERAPEUTIC USE"
